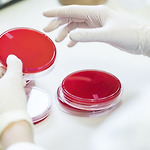

Notice
Recent Posts
Recent Comments
Link
목록성기사마귀 (1)
스마트맨의원
성기 사마귀, 뾰루지 원인이 멀까요 ?
성기 사마귀, 뾰루지 원인이 멀까요 ?
성기에 사마귀나 뾰루지, 물집같은 것이 잡혀 문의를 주시는 분들이 있습니다. 혹시 성병은 아닐까 의심하는 경우가 많은데요. 하지만 이를 육안으로만 관찰하여 단정짓기는 힘듭니다. 또한 성기 사마귀는 소견명이지 진단명은 아닙니다. 항문생식기 부위의 사마귀 형태의 소견이 있는 경우 크게 6가지를 의심해 볼 수 있습니다. 1. 첨규 콘딜로마 - HPV 원인 2. 편평콘딜로마 - 2차 매독 3. Molluscum contagiosum 4. 쥐젖 5. 암종 6. 정상조직의 변이 따라서 이러한 증상이 있다면 조직 검사를 통해 확정진단을 내려야 합니다. 대표적으로 HPV 바이러스가 원인이 되는 첨규 콘딜로마의 증상을 꼽을 수 있습니다. 이는 대부분 성관계를 통해 전파되며,성기 사마귀 곤지름은 바이러스를 없앨수 없기 때..
성병정보
2020. 5. 4. 13:30

